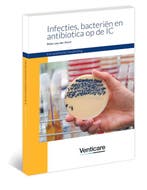
Infecties, bacteriën en antibiotica op de IC 9789072651372, Boeken, Verzenden, Gelezen, Peter van der Voort

42,1%
Van alle Beademing advertenties is 42,1% beschikbaar voor verzending.
≥ Beademing in Boeken | Marktplaats
Ontdek boeken over beademing en gerelateerde onderwerpen. Leer over de techniek, toepassingen en meer in ons aanbod boeken. Verhoog uw kennis met deze titels.